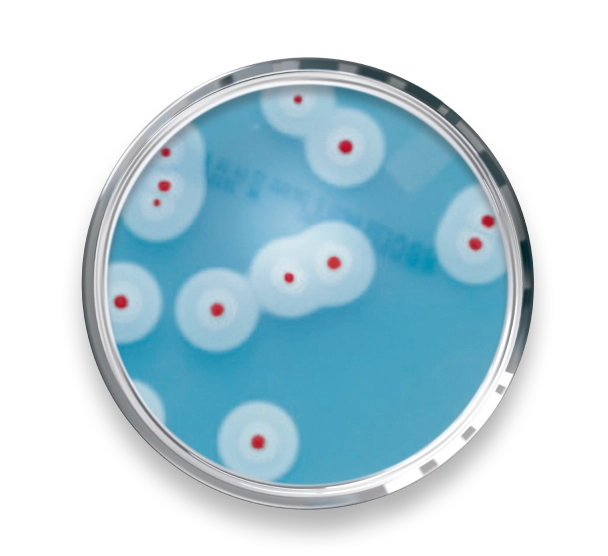
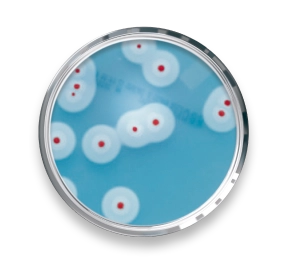
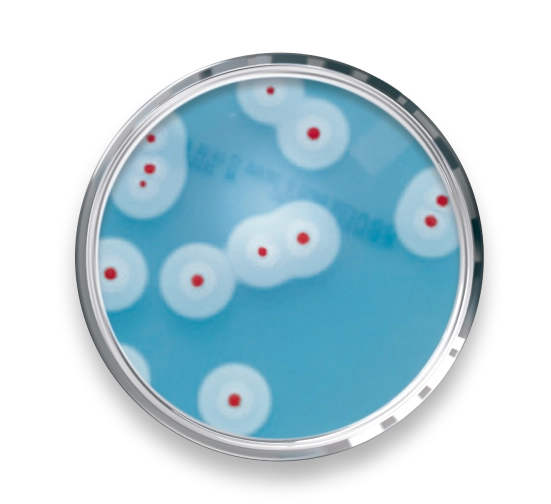
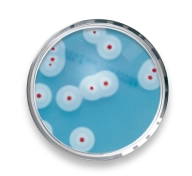

Aproveite as condições promocionais!

A revolução em testes microbiológicos para a indústria de alimentos.
Você precisa de resultados rápidos, precisos e validados internacionalmente?
Atenda às demandas da Indústria com a agilidade que você precisa e a confiança que o consumidor merece!
Resultados completos em até 24h! Incubação rápida, sem necessidade de enriquecimento e confirmação.
Primeiro meio cromogênico que permite a enumeração de todas as espécies patogênicas de Bacillus cereus, incluindo Bacillus cytotoxicus.
Permite inoculação de superfície e protocolos de pour plate com armazenamento até 72h a 2-8ºC antes da leitura.
NF Validation.
Impede o crescimento excessivo das colônias, facilitando o isolamento;
Além disso, não precisa ser plaqueado em duplicata como na metodologia ISO.
Maior facilidade para enumeração em função do contraste.

O portal FeedFood destacou o RAPID’B.cereus em uma matéria sobre a pesquisa presuntiva do grupo B.cereus e uma forma de eliminar as dificuldades para distinguir colônias típicas de atípicas de B.cereus.

Conheça nossas ofertas especiais e condições exclusivas para a linha RAPID’. Aproveite essa oportunidade única para elevar sua análise de segurança de alimentos a um novo patamar.
Porque sabemos muito bem do que estamos falando! Confira você mesmo:

CARTILHA
Faça o download gratuito da cartilha e descubra como RAPID’B.cereus valoriza o seu tempo.

CARTILHA
Baixe grátis nossa cartilha
e desvende o RAPID’E.coli 2.

CARTILHA
Baixe grátis nossa cartilha
e desvende o RAPID’Salmonella.

WEBINAR EXCLUSIVO
Acesse este webinar exclusivo e aproveite a oportunidade ideal para conhecer mais sobre os aspectos biológicos, metodologias de análise e parâmetros da legislação vigente para B.cereus. Ideal para estudantes e profissionais atuantes em laboratórios e indústria de alimentos.

WEBINAR EXCLUSIVO
Você está pronto(a) para elevar suas análises microbiológicas a um novo patamar de eficiência? Desbloqueie gratuitamente seu acesso ao Webinar “Otimização do Workflow de Análises Microbiológicas a partir da Cultura Tradicional”, com o expert Marcelo Silva, e eleve o padrão das suas análises microbiológicas de alimentos!

CURSO
Inscreva-se no curso da Universidade Bio-Rad e garanta seu certificado gratuitamente. São dois módulos repletos de conhecimentos técnicos e científicos em conceitos atuais da Segurança dos Alimentos, principalmente no nicho de análises microbiológicas, com aulas dinâmicas preparadas por experts da Bio-Rad, mestres e doutores em diferentes áreas da Ciência.

WEBINAR EXCLUSIVO
Aprenda mais sobre a importância do Bacillus cereus nos testes de patógenos alimentares, cenário regulatório global, como verificar e implementar uma metodologia para testes de B. cereus em seu laboratório e quais vantagens o RAPID’B.cereus traz para sua rotina de trabalho, com a participação de Daniel Smieszek, Supervisor de Operação do Nestlé Quality Assurance Centre de Dublin, Ohio.

Entre em contato conosco hoje mesmo e descubra os benefícios do RAPID’B.cereus da Bio-Rad.

| Cookie | Duração | Descrição |
|---|---|---|
| cookielawinfo-checkbox-analytics | 11 months | This cookie is set by GDPR Cookie Consent plugin. The cookie is used to store the user consent for the cookies in the category "Analytics". |
| cookielawinfo-checkbox-functional | 11 months | The cookie is set by GDPR cookie consent to record the user consent for the cookies in the category "Functional". |
| cookielawinfo-checkbox-necessary | 11 months | This cookie is set by GDPR Cookie Consent plugin. The cookies is used to store the user consent for the cookies in the category "Necessary". |
| cookielawinfo-checkbox-others | 11 months | This cookie is set by GDPR Cookie Consent plugin. The cookie is used to store the user consent for the cookies in the category "Other. |
| cookielawinfo-checkbox-performance | 11 months | This cookie is set by GDPR Cookie Consent plugin. The cookie is used to store the user consent for the cookies in the category "Performance". |
| viewed_cookie_policy | 11 months | The cookie is set by the GDPR Cookie Consent plugin and is used to store whether or not user has consented to the use of cookies. It does not store any personal data. |
Preencha o formulário e receba o material!
Preencha o formulário e receba o material!
Preencha o formulário e receba o material!